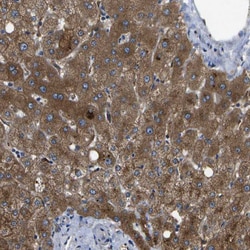
Invitrogen HFE Polyclonal Antibody 100 &mu;L; Unconjugated:Antibodies,

missing translation for 'onlineSavingsMsg'
Learn More
Learn More
Invitrogen™ HFE Polyclonal Antibody


Rabbit Polyclonal Antibody
Brand: Invitrogen™ PA582581
This item is not returnable.
View return policy
Description
Immunogen sequence: YLERDCPAQL QQLLELGRGV LDQQVPPLVK VTHHVTSSVT TLRCRALNYY PQNITMKWLK DKQPMDAKEF EPKDVLPNGD GTYQGWITLA VPPGEEQRYT CQVEHPGLDQ PLIVIWEPSP S Highest antigen sequence indentity to the following orthologs: Rat - 73%, Mouse - 71%.
The protein encoded by this gene is a membrane protein that is similar to MHC class I-type proteins and associates with beta2-microglobulin. It is thought that this protein functions to regulate iron absorption by regulating the interaction of the transferrin receptor with transferrin. The iron storage disorder, hereditary haemochromatosis, is a recessive genetic disorder that results from defects in this gene. At least nine alternatively spliced variants have been described for this gene. Additional variants have been found but their full-length nature has not been determined.
Specifications
| HFE | |
| Polyclonal | |
| Unconjugated | |
| HFE | |
| hemochromatosis; hereditary hemochromatosis protein; hereditary hemochromatosis protein HLA-H; hereditary hemochromatosis protein homolog; Hfe; HFE 1; HFE1; HH; high Fe; HLA H; HLAH; HLA-H; MGC:150812; MGC10379; MGC103790; MHC class I-like protein HFE; Mr2; MVCD7; RT1-CAFE; TFQTL2 | |
| Rabbit | |
| Antigen affinity chromatography | |
| RUO | |
| 3077 | |
| Store at 4°C short term. For long term storage, store at -20°C, avoiding freeze/thaw cycles. | |
| Liquid |
| Immunohistochemistry (Paraffin), Western Blot | |
| 0.1 mg/mL | |
| PBS with 40% glycerol and 0.02% sodium azide; pH 7.2 | |
| Q30201 | |
| HFE | |
| Recombinant protein corresponding to Human HFE. Recombinant protein control fragment (Product #RP-89957). | |
| 100 μL | |
| Primary | |
| Human | |
| Antibody | |
| IgG |
Product Content Correction
Your input is important to us. Please complete this form to provide feedback related to the content on this product.
Product Title
Spot an opportunity for improvement?Share a Content Correction